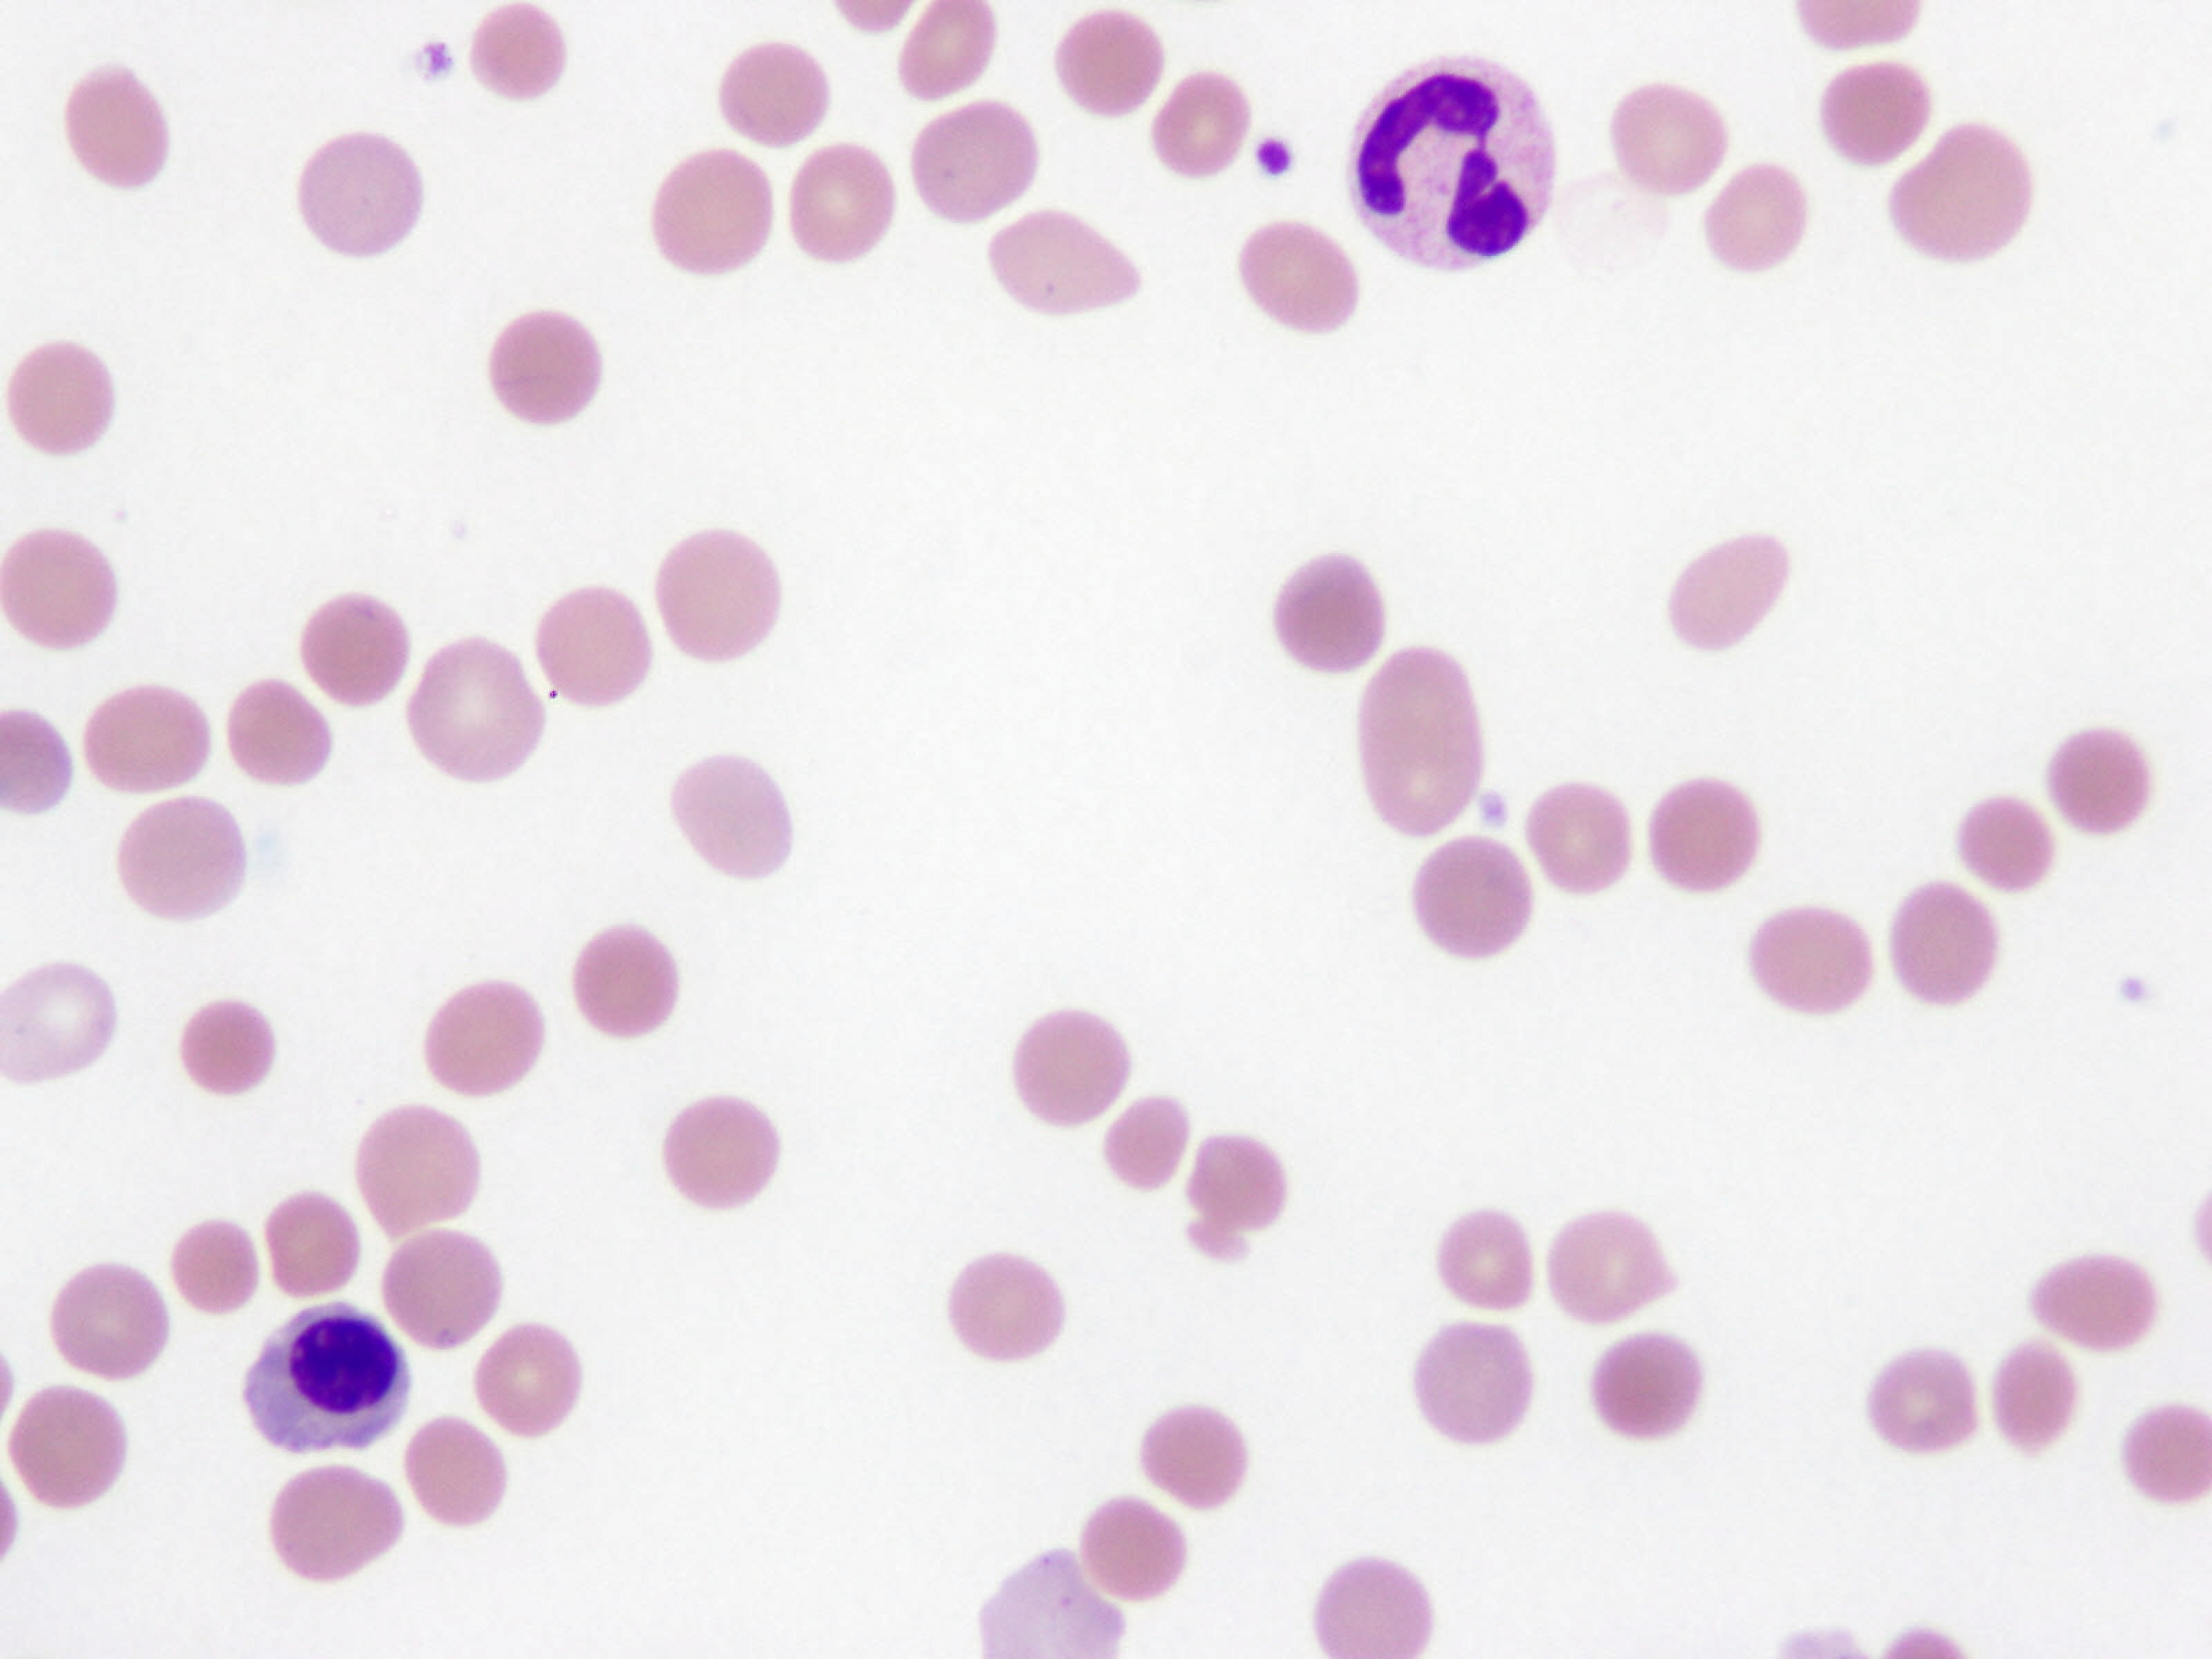

Summary
What are blood group antigens and antibodies?
Your immune system protects you by making antibodies to attack substances that should not be in your body and could be harmful to you. This includes infections like viruses and bacteria as well as toxic substances. It does this by targeting special markers called antigens which are found on the surfaces of most cells.
Your blood cells have marker antigens on their surface. Blood is made up of different cells including red blood cells, white blood cells and platelets suspended in a liquid called plasma.
Everyone has their own set of marker antigens on their red blood cells which are inherited from their parents. There are about 30 blood group types, but A, B, AB and O are the most common.
Blood groups
Each of these blood types is then further classified according to whether your red blood cells have the Rhesus D (RhD) marker antigen, also known as RhD factor. If you are RhD-positive your blood cells have RhD antigens. If you are RhD-negative, your blood cells do not have the RhD antigen.
Why get tested?
Haemolytic anaemia is a condition in which red blood cells are destroyed more quickly than they can be replaced.
The Direct Antiglobulin Test (DAT) is used to help decide whether the cause of haemolytic anaemia is due to antibodies attached to red blood cells.
If you have had a blood transfusion in the past from donor blood that was from a blood group different from your own, it is possible that your body made antibodies against it.
If you have previously been pregnant and your baby inherited a different type of blood to yours from their father, your body may have made antibodies against it. This may not have been a problem at the time but if you are pregnant again and your next baby has also has a different blood group from your own, they could be harmed by a condition called haemolytic disease of the foetus and newborn (HDFN).
For more on blood types, transfusion reactions and screening in pregnancy see Antenatal blood group and screen and Red cell antibody screen.
Having the test
Sample
A blood sample taken by a needle placed in a vein in the arm or by a finger-prick (for children and adults) or heel-prick (for infants).
Any preparation?
None.
Your results
The results of the test are reported as negative or positive. The strength of the positive result and the type of antibody present may also be reported.
A positive DAT indicates you have antibodies on your red cells which could be the cause of the red cell destruction.
The strength of the positive result reflects the amount of antibody on the red cells. However, this does not always mean your symptoms will be more severe, especially if the red blood cells have already been destroyed. The type of antibody can help in diagnosing the cause of red cell destruction.
Treatment of the cause will vary, but in the case of HDFN, the condition needs to be monitored and treated to prevent possible complications.
Some people will be DAT-positive and not experience haemolytic anaemia.
A negative DAT means that antibodies are most likely not attached to your red blood cells and your symptoms are due to another cause which requires further investigation.
More to know?
A positive DAT in the case of a transfusion reaction or due to a medication can remain positive for days to months, whereas in someone with an autoimmune condition, the test may stay positive for longer.
Questions to ask your doctor
The choice of tests your doctor makes will be based on your medical history and symptoms. It is important that you tell them everything you think might help.
You play a central role in making sure your test results are accurate. Do everything you can to make sure the information you provide is correct and follow instructions closely.
Talk to your doctor about any medications you are taking. Find out if you need to fast or stop any particular foods or supplements. These may affect your results. Ask:
More information
Pathology and diagnostic imaging reports can be added to your My Health Record. You and your healthcare provider can now access your results whenever and wherever needed.
Get further trustworthy health information and advice from healthdirect.
What is Pathology Tests Explained?
Pathology Tests Explained (PTEx) is a not-for profit group managed by a consortium of Australasian medical and scientific organisations.
With up-to-date, evidence-based information about pathology tests it is a leading trusted source for consumers.
Information is prepared and reviewed by practising pathologists and scientists and is entirely free of any commercial influence.